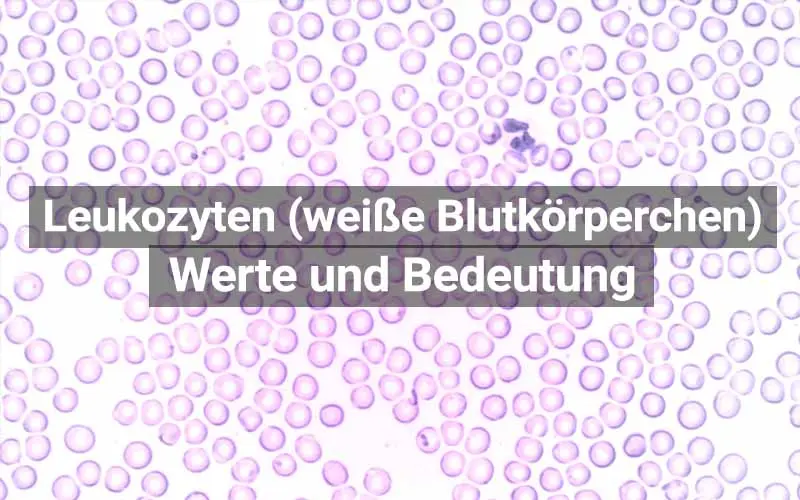
leukozyten schwangerschaft - Wann sind die Leukozyten erhöht

Die Schwangerschaft ist eine Zeit großer Veränderungen im Körper einer Frau. Viele dieser Veränderungen betreffen auch das Blutbild. Eine wichtige Komponente des Blutbildes sind die Leukozyten, auch bekannt als weiße Blutkörperchen. Sie spielen eine entscheidende Rolle bei der Abwehr von Infektionen und anderen Krankheitserregern. Während der Schwangerschaft kann es zu einer erhöhten Leukozytenzahl kommen. Dies ist in den meisten Fällen ein normaler und gesunder Prozess, der den Körper der schwangeren Frau vor Infektionen schützt. Allerdings können erhöhte Leukozyten-Werte auch auf andere Erkrankungen hinweisen. In diesem Artikel erfahren Sie alles Wissenswerte über Leukozyten in der Schwangerschaft, ihre Bedeutung und mögliche Ursachen für erhöhte oder erniedrigte Werte.
- Die Rolle von Leukozyten in der Schwangerschaft
- Ursachen für erhöhte Leukozyten in der Schwangerschaft
- Symptome erhöhter Leukozyten in der Schwangerschaft
- Diagnose von erhöhten Leukozyten in der Schwangerschaft
- Behandlung von erhöhten Leukozyten in der Schwangerschaft
- Leukozyten in der Schwangerschaft:
- Was bedeutet es, wenn meine Leukozytenzahl in der Schwangerschaft erhöht ist?
- Wie werden Leukozyten in der Schwangerschaft gemessen?
- Was kann ich tun, wenn meine Leukozytenzahl in der Schwangerschaft erhöht ist?
- Kann eine erhöhte Leukozytenzahl in der Schwangerschaft gefährlich für das ungeborene Kind sein?
- Kann eine erhöhte Leukozytenzahl in der Schwangerschaft zu Frühgeburten führen?
- Fazit
Die Rolle von Leukozyten in der Schwangerschaft
Leukozyten sind eine wesentliche Komponente des Immunsystems. Sie sind dafür verantwortlich, den Körper vor Krankheitserregern wie Bakterien, Viren und Pilzen zu schützen. Während der Schwangerschaft durchläuft das Immunsystem der Frau eine Reihe von Veränderungen, um die Entwicklung des Fötus zu unterstützen und gleichzeitig die Mutter und das ungeborene Kind vor Infektionen zu schützen. Diese Veränderungen können zu einer erhöhten Leukozytenzahl führen.
Arten von Leukozyten
Es gibt verschiedene Arten von Leukozyten, die jeweils unterschiedliche Funktionen im Immunsystem erfüllen. Zu den wichtigsten Arten gehören:
- Neutrophile : Diese Leukozyten sind die häufigsten und bekämpfen vor allem bakterielle Infektionen.
- Lymphozyten : Sie sind für die spezifische Immunantwort verantwortlich und erkennen und bekämpfen bestimmte Krankheitserreger.
- Monozyten : Diese Leukozyten entwickeln sich zu Makrophagen, die Krankheitserreger aufnehmen und zerstören.
- Eosinophile : Sie sind an der Abwehr von Parasiten und allergischen Reaktionen beteiligt.
- Basophile : Diese Leukozyten setzen Histamin frei, ein Botenstoff, der an Entzündungsreaktionen beteiligt ist.
Erhöhte Leukozytenzahl in der Schwangerschaft: Normal oder Besorgnis erregend?
Eine erhöhte Leukozytenzahl in der Schwangerschaft ist in vielen Fällen ein normales Phänomen. Der Körper der schwangeren Frau passt sich den veränderten Bedingungen an und verstärkt seine Abwehrkräfte, um sich und das ungeborene Kind vor Infektionen zu schützen.

Es gibt jedoch auch Fälle, in denen eine erhöhte Leukozytenzahl auf eine Erkrankung hindeuten kann. Daher ist es wichtig, dass die Leukozyten-Werte im Blut regelmäßig kontrolliert werden, um mögliche Probleme frühzeitig zu erkennen.
Ursachen für erhöhte Leukozyten in der Schwangerschaft
Es gibt verschiedene Gründe, warum die Leukozytenzahl in der Schwangerschaft erhöht sein kann. Einige davon sind normal und harmlos, während andere auf eine Erkrankung hinweisen können. Zu den häufigsten Ursachen gehören:

- Normale Schwangerschaftsveränderungen : Der Körper der schwangeren Frau produziert mehr Leukozyten, um das Immunsystem zu stärken und das ungeborene Kind vor Infektionen zu schützen.
- Infektionen : Infektionen während der Schwangerschaft, wie z.B. Harnwegsinfektionen, können zu einer erhöhten Leukozytenzahl führen.
- Entzündungen : Entzündungen im Körper, wie z.B. Eine Zahnfleischentzündung, können ebenfalls zu einer erhöhten Leukozytenzahl führen.
- Stress : Stress kann das Immunsystem beeinflussen und zu einer erhöhten Leukozytenzahl führen.
- Medikamente : Einige Medikamente, wie z.B. Kortison, können die Leukozytenzahl erhöhen.
- Seltene Erkrankungen : In seltenen Fällen kann eine erhöhte Leukozytenzahl auf eine ernsthafte Erkrankung hinweisen, z.B. Leukämie oder eine andere Art von Blutkrebs.
Symptome erhöhter Leukozyten in der Schwangerschaft
Eine erhöhte Leukozytenzahl in der Schwangerschaft verursacht in der Regel keine spezifischen Symptome. Wenn jedoch eine erhöhte Leukozytenzahl auf eine zugrunde liegende Erkrankung hinweist, können Symptome wie Fieber, Müdigkeit, Gewichtsverlust, Schwellungen der Lymphknoten, Schmerzen in den Knochen oder Atemnot auftreten.
Diagnose von erhöhten Leukozyten in der Schwangerschaft
Eine erhöhte Leukozytenzahl wird in der Regel durch ein Blutbild festgestellt. Bei Verdacht auf eine zugrunde liegende Erkrankung können weitere Untersuchungen, wie z.B. Eine Urinanalyse, eine Röntgenaufnahme oder eine Biopsie, durchgeführt werden.
Behandlung von erhöhten Leukozyten in der Schwangerschaft
Die Behandlung von erhöhten Leukozyten in der Schwangerschaft hängt von der Ursache ab. In vielen Fällen ist keine Behandlung erforderlich, da die erhöhte Leukozytenzahl auf normale Schwangerschaftsveränderungen zurückzuführen ist. Wenn jedoch eine zugrunde liegende Erkrankung vorliegt, wird diese behandelt.
Leukozyten in der Schwangerschaft:
Was bedeutet es, wenn meine Leukozytenzahl in der Schwangerschaft erhöht ist?
Eine erhöhte Leukozytenzahl in der Schwangerschaft ist in den meisten Fällen ein normales Phänomen und kein Grund zur Sorge. Der Körper der schwangeren Frau produziert mehr Leukozyten, um das Immunsystem zu stärken und das ungeborene Kind vor Infektionen zu schützen. In einigen Fällen kann eine erhöhte Leukozytenzahl jedoch auch auf eine zugrunde liegende Erkrankung hinweisen.
Wie werden Leukozyten in der Schwangerschaft gemessen?
Die Leukozytenzahl wird durch ein Blutbild gemessen. Dieses wird in der Regel während der regelmäßigen Schwangerschaftsuntersuchungen durchgeführt.
Was kann ich tun, wenn meine Leukozytenzahl in der Schwangerschaft erhöht ist?
Wenn Ihre Leukozytenzahl in der Schwangerschaft erhöht ist, sollten Sie Ihren Arzt aufsuchen. Er wird die Ursache der erhöhten Leukozytenzahl untersuchen und gegebenenfalls eine Behandlung einleiten.
Kann eine erhöhte Leukozytenzahl in der Schwangerschaft gefährlich für das ungeborene Kind sein?
In den meisten Fällen ist eine erhöhte Leukozytenzahl in der Schwangerschaft nicht gefährlich für das ungeborene Kind. Wenn jedoch die erhöhte Leukozytenzahl auf eine zugrunde liegende Erkrankung hinweist, kann diese für das ungeborene Kind gefährlich sein. Daher ist es wichtig, dass Sie Ihren Arzt aufsuchen, wenn Sie Bedenken haben.
Kann eine erhöhte Leukozytenzahl in der Schwangerschaft zu Frühgeburten führen?
Es gibt keine eindeutigen Beweise dafür, dass eine erhöhte Leukozytenzahl in der Schwangerschaft zu Frühgeburten führt. Wenn jedoch die erhöhte Leukozytenzahl auf eine zugrunde liegende Erkrankung hinweist, kann diese zu Frühgeburten führen.
Fazit
Eine erhöhte Leukozytenzahl in der Schwangerschaft ist in den meisten Fällen ein normales Phänomen und kein Grund zur Sorge. Es ist jedoch wichtig, dass die Leukozyten-Werte im Blut regelmäßig kontrolliert werden, um mögliche Probleme frühzeitig zu erkennen. Wenn Sie Bedenken haben oder Symptome auftreten, sollten Sie Ihren Arzt aufsuchen.
Dieser Artikel dient ausschließlich zu Informationszwecken und ersetzt keine professionelle medizinische Beratung. Wenn Sie Fragen oder Bedenken haben, wenden Sie sich bitte an Ihren Arzt.
Wenn Sie andere Artikel kennenlernen möchten, die Leukozyten in der schwangerschaft: ursachen & bedeutung ähneln, können Sie die Kategorie Schwangerschaft & blutwerte besuchen.
